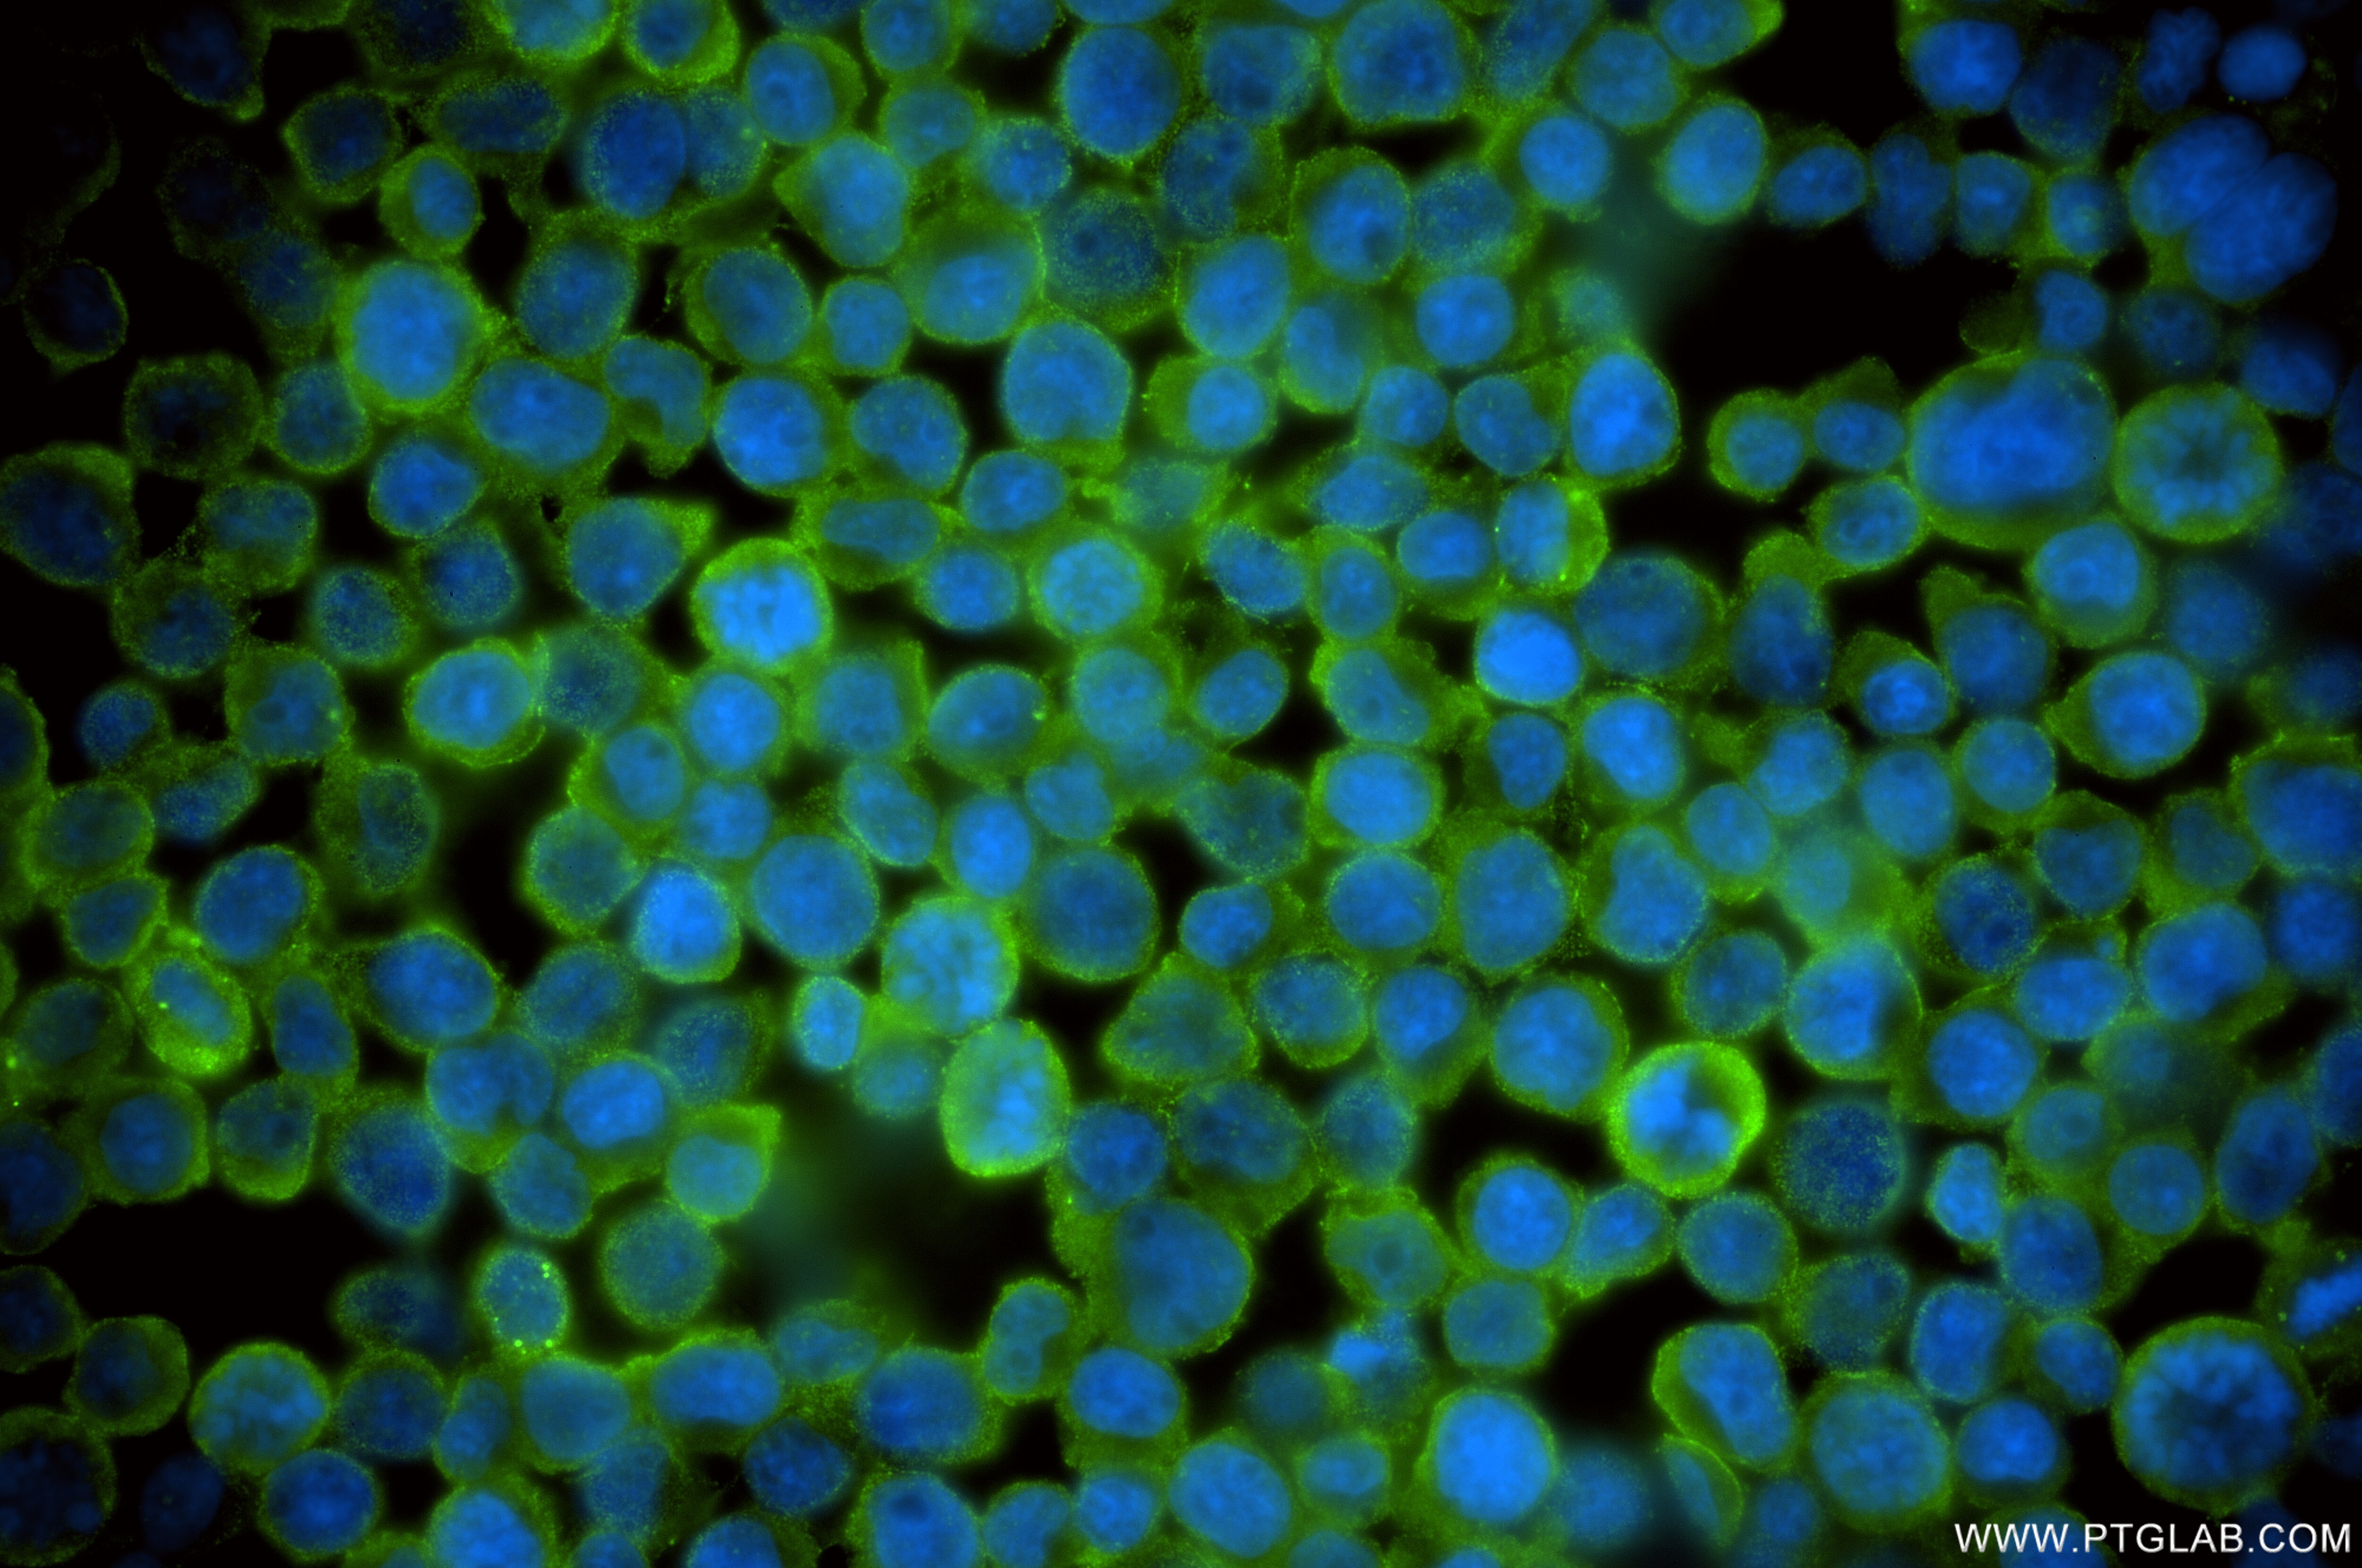
Immunofluorescence (IF) / fluorescent staining of Jurkat cells using RTCB Recombinant antibody (86258-4-RR)

Tested Applications
| Positive WB detected in | Jurkat cells, HeLa cells, HEK-293T cells, 3T3-L1 cells, mouse brain tissue, rat brain tissue |
| Positive IF/ICC detected in | Jurkat cells |
Recommended dilution
| Application | Dilution |
|---|---|
| Western Blot (WB) | WB : 1:5000-1:50000 |
| Immunofluorescence (IF)/ICC | IF/ICC : 1:250-1:1000 |
| It is recommended that this reagent should be titrated in each testing system to obtain optimal results. | |
| Sample-dependent, Check data in validation data gallery. | |
Product Information
86258-4-RR targets RTCB in WB, IF/ICC, ELISA applications and shows reactivity with human, mouse, rat samples.
| Tested Reactivity | human, mouse, rat |
| Host / Isotype | Rabbit / IgG |
| Class | Recombinant |
| Type | Antibody |
| Immunogen |
CatNo: Ag13836 Product name: Recombinant human C22orf28 protein Source: e coli.-derived, PGEX-4T Tag: GST Domain: 159-505 aa of BC000151 Sequence: GVIPMNAKDLEEALEMGVDWSLREGYAWAEDKEHCEEYGRMLQADPNKVSARAKKRGLPQLGTLGAGNHYAEIQVVDEIFNEYAAKKMGIDHKGQVCVMIHSGSRGLGHQVATDALVAMEKAMKRDKIIVNDRQLACARIASPEGQDYLKGMAAAGNYAWVNRSSMTFLTRQAFAKVFNTTPDDFDLHVIYDVSHNIAKVEQHVVDGKERTLLVHRKGSTRAFPPHHPLIAVDYQLTGQPVLIGGTMGTCSYVLTGTEQGMTETFGTTCHGAGRALSRAKSRRNLDFQDVLDKLADMGIAIRVASPKLVMEEAPESYKNVTDVVNTCHDAGISKKAIKLRPIAVIKG Predict reactive species |
| Full Name | chromosome 22 open reading frame 28 |
| Calculated Molecular Weight | 55 kDa |
| Observed Molecular Weight | 55 kDa |
| GenBank Accession Number | BC000151 |
| Gene Symbol | RTCB |
| Gene ID (NCBI) | 51493 |
| Conjugate | Unconjugated |
| Form | Liquid |
| Purification Method | Protein A purification |
| UNIPROT ID | Q9Y3I0 |
| Storage Buffer | PBS with 0.02% sodium azide and 50% glycerol, pH 7.3. |
| Storage Conditions | Store at -20°C. Stable for one year after shipment. Aliquoting is unnecessary for -20oC storage. 20ul sizes contain 0.1% BSA. |
Background Information
RTCB (also known as HSPC117, C22orf28, FAAP and D10Wsu52e) is an essential subunit of a tRNA ligase complex that is involved in RNA repair and stress-induced splicing. As a multifunctional protein, RTCB is also a cell adhesion protein and is important in embryo and placenta development. Recently RTCB has been identified as UPR RNA ligase catalyzing unconventional XBP1 mRNA splicing. This antibody specifically recognizes endogenous RTCB protein. (25087875)